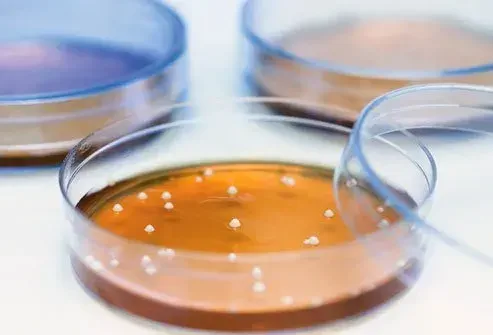

Les Informations Présentées Sur Ce Site Ne Constituent Pas Un Avis Médical. Nous Ne Vendons Rien. L'Exactitude De La Traduction N'Est Pas Garantie. Clause De Non-Responsabilité
Médicaments
Santé de la peau: les créatures qui vivent sur votre corps
Poux de tête

Ces minuscules insectes peuvent vivre dans vos cheveux et boire du sang de votre cuir chevelu. Ils ne sont généralement pas dangereux qui démangent et contagieux. Ils sont communs chez les écoliers primaires. Vous pouvez acheter des shampooings sur le comptoir qui les tuent et votre médecin peut vous parler de celles d'ordonnance. Vous devrez utiliser un peigne à dents fines humide (appelé un peigne NIT) sur vos cheveux pour vous en débarrasser.
Même si vous le faites, ils peuvent également pondre des œufs. S'ils éclosent, vous démangerez à nouveau.
Teigne

Ne t'inquiète pas. Ce n'est pas vraiment un ver. C'est un champignon qui peut infecter à peu près n'importe quelle partie de votre corps. Sur votre tête, cela pourrait faire tomber les cheveux dans le motif d'anneau distinct qui lui donne son nom. Sur vos pieds, cela s'appelle le pied de l'athlète et dans votre coin entrejambe, c'est des démangeaisons de jock.
Votre médecin ou pharmacien peut vous aider à vous débarrasser avec des crèmes antifongiques pulvérices ou des pilules.
Ankylostome

Ceci est rare aux États-Unis, mais les larves de recouvrement - généralement trouvées en Asie Afrique et au Moyen-Orient - peuvent entrer souvent dans votre peau lorsque vous marchez pieds nus sur le sol qui a infecté du caca. Ils vivent dans votre intestin ne sont généralement pas dangereux et disparaissent souvent sans traitement.
La créature peut vous faire démanger et rouge où il est entré dans votre peau. Vous pouvez également tousser siffler et avoir des douleurs à l'estomac.
Parlez à votre médecin si vous pensez l'avoir.
Ténia

Vous pouvez obtenir ce parasite à partir du porc de bœuf ou du poisson infecté. Si vous l'avez, vous verrez probablement de minuscules œufs et morceaux de ver dans votre caca.
Un ver peut atteindre 30 pieds de long en vous et provoquer des crampes de diarrhée et une perte de poids.
Votre médecin peut vous donner de la drogue pour vous en débarrasser. Le traitement précoce est important car il pourrait entraîner des kystes cérébraux qui peuvent provoquer des convulsions et une confusion. Il peut également apporter une maladie potentiellement mortelle.
Acariens

Également connus sous le nom de Demodex, ce sont essentiellement de minuscules araignées que vous prenez à mesure que vous vieillissez. À 60 ans, vous avez quelques milliers des petits gars qui vivent sur votre visage. Vous ne pouvez pas les voir parce qu'ils ne sont qu'environ un tiers d'un millimètre de long et transparent.
Ils ne se soucient pas. Tout ce qu'ils veulent, c'est manger des cellules mortes de la peau et un peu d'huile qui les accompagnent.
Gale

Le bien nommé `` Human Itch acarin '' utilise ses huit jambes pour creuser dans la couche supérieure de votre peau pour se nourrir dans vos aisselles de l'aine entre vos doigts ou vos orteils ou sous votre ceinture.
Votre corps répond par une éruption cutanée. Vous pourriez l'obtenir d'une autre personne si vous touchez sa peau ou des vêtements ou des meubles. Votre médecin peut dire si vous l'avez et que les médicaments sur ordonnance peuvent s'en débarrasser. Laver la literie et les vêtements pour terminer le travail.
Giardia

Ce sont de minuscules petits parasites qui vivent dans votre intestin. Vous pouvez les obtenir si vous nagez ou buvez dans certains ruisseaux et lacs. Vous pourriez également les obtenir des bains à remous de puits d'eau des piscines contaminées et un contact avec une personne infectée.
Giardia can give you cramps gas weight loss sulfur-smelling burps and foul-smelling diarrhea. Then again you may not have any symptoms.
Combien de bore dois-je prendre
Bactéries du ventre

Dans les plis de vos glandes nombrillles font de l'huile de sueur et d'autres choses qui attirent des bactéries et en repoussent d'autres. Certains d'entre eux pourraient vous rendre malade dans d'autres endroits. Mais ici, ils pourraient aider à lutter contre des germes plus dangereux. Des choses comme votre sexe votre maquillage du corps là où vous vivez et vos gènes peuvent déterminer les bactéries - et quelle part - vous aurez.
Candida: le champignon parmi nous

Cela prospère dans des endroits humides chauds foncés comme votre bouche les plis de votre peau et de votre entrejambe. Il provoque une éruption de peau sèche gonflée. Dans votre bouche, il pourrait trop grandir et provoquer des taches de bosses blanches qui démangent sur la gorge de votre langue ou à l'intérieur de vos joues. Vous pouvez entendre votre médecin appeler cela «muguet». Il peut être traité avec des médicaments antifongiques.
Chez les adultes, cette condition est rare. Lorsqu'il se produit, il est généralement associé à l'immunocompromis à partir de: la chimiothérapie du diabète incontrôlé ou une mauvaise utilisation de stéroïdes inhalés.
Microbiome intestinal

La plupart des milliers de milliers de choses microscopiques qui vivent dans votre corps sont à l'intérieur de votre intestin. Ils interagissent avec votre alimentation votre corps et l'environnement extérieur. Les chercheurs trouvent toujours comment.
Tout le monde a un microbiome intestinal. Vous pourriez avoir un microbiome sain ou moins sain et vous pouvez manipuler à la fois des antibiotiques alimentaires et même des greffes de selles avec la supervision de votre médecin.
Créatures en bouche

Un délicat équilibre entre les champignons et les virus des bactéries vivent tout le temps dans votre bouche. Des problèmes tels que les cavités ou les plaies peuvent commencer lorsque cet équilibre est éloigné. Cela peut se produire en raison de choses comme le diabète de la bouche sèche ou un système immunitaire faible.
Bactéries lactobacilles
Un bon équilibre et une variété de créatures microscopiques vivent à l'intérieur du vagin. Ils sont considérés comme la première ligne de défense contre d'autres microbes qui pourraient vous donner une décharge vaginale malodorante et des démangeaisons. Les bactéries de lactobacilles en particulier favorisent la santé vaginale car elles aident à maintenir les niveaux d'acide juste. Cela peut aider à prévenir la vaginose bactérienne et les infections à levures.
Aisse microbiome

L'équilibre des créatures dans votre bouche et votre instinct ne sont pas les seuls qui comptent. Même vos aisselles ont un microbiome qui fait partie de la raison de l'odeur qui vient de là. Le mélange est souvent dominé par les bactéries staphiques. Mais cela peut changer radicalement si vous utilisez un anti-spirant.
Santé de la peau: les créatures qui vivent sur votre corps
Sources: 
Images fournies par:
- James Webb / Images médicales
- Rodrigobellizzi / Thinkstock
- Kateryna Kon / Science Science
- James H. Robinson / Science Science
- Oeil de science / source scientifique
- John Bavosi / source scientifique
- Professeurs P.M. Motte
- CONTEXTE: Naked King / Thinkstock Encart: DR_MICROBE / Thinkstock
- Timoninairyna / Thinkstock
- Chrischrisw / Thinkstock
- ClSgraphics / Thinkstock
- Natalime / thinkstock
- Contexte: Mheim3011 / ThinkStock Fourdre: DR_MICROBE / Thinkstock
Références:
- American Academy of Dermatology: 'Scabies' 'Seigne'.
- Revue annuelle de la microbiologie: «Le microbiome vaginal: repenser la santé et les maladies».
- Journal dentaire britannique: «Le microbiome oral - une mise à jour pour les professionnels de la santé orale».
- CDC: «Parasites: ankylosto» «Parasites - ankylostomes zoonotiques».
- HealthGuidance.org: «Rencontrez les bugs qui vivent dans vos sourcils».
- JOHNS HOPKINS ABX Guide: «Sarcoptes Scabiei Var Hominis (Scabies)« Vaginose bactérienne »« Terrue ».
- Clinique Mayo: «Giardia» «Mugue» «Infections staphiques» «Infection par SARM» «vaginose bactérienne» «espèce de candida».
- Merck Manual: «Infection par l'étalonnage».
- Blog du réalisateur du NIH: Oui, c'est vrai: il y a des champignons parmi nous.
- Université d'État de Caroline du Nord: «Diversité microbienne dans le nombril».
- Revues de nutrition: «Définition du microbiome humain».
- Peerj (Journal): «L'effet de l'utilisation habituelle et expérimentale des anti-ventre et des produits déodorants sur le microbiome aisselle».
- PLOS ONE: Une jungle là-dedans: les bactéries dans les boutons du ventre sont très diverses mais prévisibles.
- La Fondation Nemours: «Péche de tête».
- Uptodate: «Éducation des patients: poux de tête (au-delà des bases)».
Cet outil ne fournit pas de conseils médicaux. Voir des informations supplémentaires: 
Cet outil ne fournit pas de conseils médicaux. Il est destiné à des fins d'information générales uniquement et ne traite pas des circonstances individuelles. Il ne remplace pas le diagnostic ou le traitement professionnel des conseils médicaux et ne doit pas être invoqué pour prendre des décisions concernant votre santé. N'ignorez jamais les conseils médicaux professionnels dans la recherche de traitement à cause de quelque chose que vous avez lu sur le site RXList. Si vous pensez avoir une urgence médicale, appelez immédiatement votre médecin ou composez le 911.
© 1996-2025 WebMD LLC . Tous droits réservés.
Source de diaporama sur WebMD
